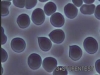
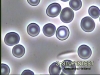

Ihr individuelles Vitalblut
Dunkelfeldmikroskopie
Die Dunkelfeldmikroskopie stellt ein ganzheitliches Verfahren zur Blutuntersuchung dar. Hier findet hauptsächlich eine qualitative Beurteilung des Blutes statt, in dem Aktivität und Funktionstüchtigkeit der Blutzellen bewertet werden. Die Blutzellen können im Dunkelfeld in Vergrößerungen bis 1000fach beobachtet werden. Der 3-Stufen-Bluttest bietet im Vergleich zur konventionellen Dunkelfeldmikroskopie eine, wie ich glaube, stark erweiterte und wesentlich verbesserte Diagnosemöglichkeit.
3-Stufen-Bluttest
Die Zukunft der Medizin liegt in der Prävention. Ein Großteil der heute vorherrschenden Erkrankungen wird durch falsche Lebensweise und ungünstige Ernährungsgewohnheiten stark begünstigt. Durch den 3-Stufen-Bluttest können in meinem Sinne wichtige Zusatzinformationen über den aktuellen Gesundheitszustand und prädisponierende Risikofaktoren gewonnen werden. Der 3-Stufen-Bluttest stellt eine sehr umfassende Untersuchung des Blutes dar und erlaubt einen tiefen Einblick in den Stoffwechsel des Menschen. Die untersuchten Blutstropfen spiegeln den aktuellen Stoffwechselzustand und die Aktivität des Immunsystems wieder.
Der 3-Stufen-Bluttest vereinigt 3 Methoden miteinander:
- Die Dunkelfeldmikroskopie
- die Möglichkeit Blutzellen im Phasenkontrast zu beobachten und
- den Blutkoagulationstest (HLB-Test nach Heitan-LaGarde-Bradford)
Die Betrachtung des Blutes im Dunkelfeld und im Phasenkontrast erlauben eine differenzierte Betrachtung und Bewertung des lebenden Blutes, der Blutkoagulationstest lässt Rückschlüsse auf die Belastung mit freien Radikalen und Störungen in bestimmten Organsystemen zu. Die Kombination dieser Methoden und das Hochleistungs-Videosystem bietet Therapeut und Patienten einen faszinierenden Einblick in das Innere des Blutes. Während des 3-Stufen-Bluttests und während der Dunkelfeldmikroskopie können Sie die Analyse Ihres Blutes live auf einem 40-Zoll Monitor verfolgen.
Blutzellen im 3-Stufen- Bluttest mit verschiedenen Beleuchtungsverfahren (Dunkelfeld, Hellfeld und Phasenkontrast) unter dem Mikroskop
Beispiele für Dunkelfeld- Aufnahmen
Beispiele für Phasenkontrast- Aufnahmen
Beispiele für Hellfeld- Aufnahmen
Durchführung
Ein Tropfen Kapillar-Blut aus der Fingerbeere wird nach einer kurzen Antrocknungszeit ohne Druck in mehreren unterschiedlich großen Tropfen auf einen Objektträger aufgebracht und zum Trocknen aufbewahrt. Unmittelbar nach dem Blutabdruck wird ein zweiter Tropfen auf einen weiteren Objekträger aufgebracht und kann nun während der Trocknungszeit des 1.Objektträgers als Vitalblut im Dunkelfeld und Phasenkontrast beobachtet und beurteilt werden. Besonders faszinierend und beeindruckend ist die Betrachtung der eigenen Blutzellen bei enormer Vergrößerung (bis 10.000fach) und unterschiedlichen Beleuchtungsverfahren. Durch die Übertragung der Bilder auf den Bildschirm bietet sich so auch für den Patienten die Möglichkeit, die Untersuchung und Beurteilung des Blutes direkt mit zu verfolgen. Form, Anzahl, Anordnung, Farbe und Aktivität der Blutzellen geben nach meiner Überzeugung Hinweise auf aktuelle Stoffwechselgeschehen und chronische Belastungen des Körpers.
3-Stufen-Bluttest aus dem Kapillar-Blut
- Aktivität neutrophiler Granulozyten
- Arteriose begünstigende Plaques
- Enzymdefizit
- Nährstoffmangel
- Bakterien
- Parasitenbelastung
- Leberbelastungen
- Darmstörungen
- Störungen des Calcium- Haushaltes
- Störungen der Schilddrüse
- Belastungen mit freien Radikalen
ROS und RO(T)S
Reactive Oxygene (Toxic) Species
Jeder Mensch produziert im eigenen Stoffwechsel täglich freie (Sauerstoff-) Radikale und zwar als Abfallprodukt normaler Stoffwechselfunktionen und gezielt von bestimmten Immunzellen zur Vernichtung von pathogenen Mikroorganismen („oxidative burst“). Diese Freien Radikale richten normalerweise im Körper keinen Schaden an, weil sie durch körpereigene antioxidative Abwehrmechanismen unschädlich gemacht werden. Darüber hinaus wird der Körper durch die veränderten Umweltbedingungen, chronische Krankheiten und bestimmte Lebensgewohnheiten mit immer mehr Freien Radikalen belastet. Besteht ein Missverhältnis zwischen der Entstehung und der Entsorgung Freier Radikale, können degenerative, entzündliche und maligne Erkrankungen gefördert werden. Bei einer kritischen Ansammlung von Freien Radikale bedeutet dies eine erhöhte Anfälligkeit für zelluläre und organische Schäden.
Begünstigende Faktoren für eine überbermäßige Bildung Freier Radikale im Körper sind:
- Rauchen
- Alkohol
- Fast-Food
- denaturierte Industriekost
- Designer-Food
- vitalstoffarme Ernährung
- Verzehr vieler Süssigkeiten
- unausgewogene, unregelmäßige Mahlzeiten
- ungenügende Bewegung
- Stress
- Schlafmangel
- geringe Flüssigkeitsaufnahme
- bestehende chronische Erkrankungen
Blutkoagulationstest
Hier kann die Bildung des Fibrinnetzes bei der Blutgerinnung beurteilt werden, ein komplizierter Prozess, an dem 12 Faktoren nacheinander kaskadenartig beteiligt sind. Durch Störungen bei der Ausbildung des Fibrinnetzes kann auf Funktionsstörungen in bestimmten Organsystemen und die Belastung des Körpers mit Freien Radikalen geschlossen werden.
Der 3-Stufen-Bluttest stellt keineswegs einen Ersatz für die konventionelle Blutdiagnostik dar, sondern versteht sich als komplementäre (ergänzende) Maßnahme oder auch zur Verlaufskontrolle bestehender Erkrankungen im Rahmen einer Verlaufsbeurteilung (Therapiekontrolle).
Ebenso wie die Dunkelfeld-Mikroskopie wird auch der 3-Stufen-Bluttest von der Schulmedizin nicht anerkannt. Dies liegt hauptsächlich an unterschiedlichen Auffassungen zum Krankheitsgeschehen und dem Fehlen schulmedizinisch anerkannter Studien.
Unterschiedliche Phänomene im HLB- Koagulationstest